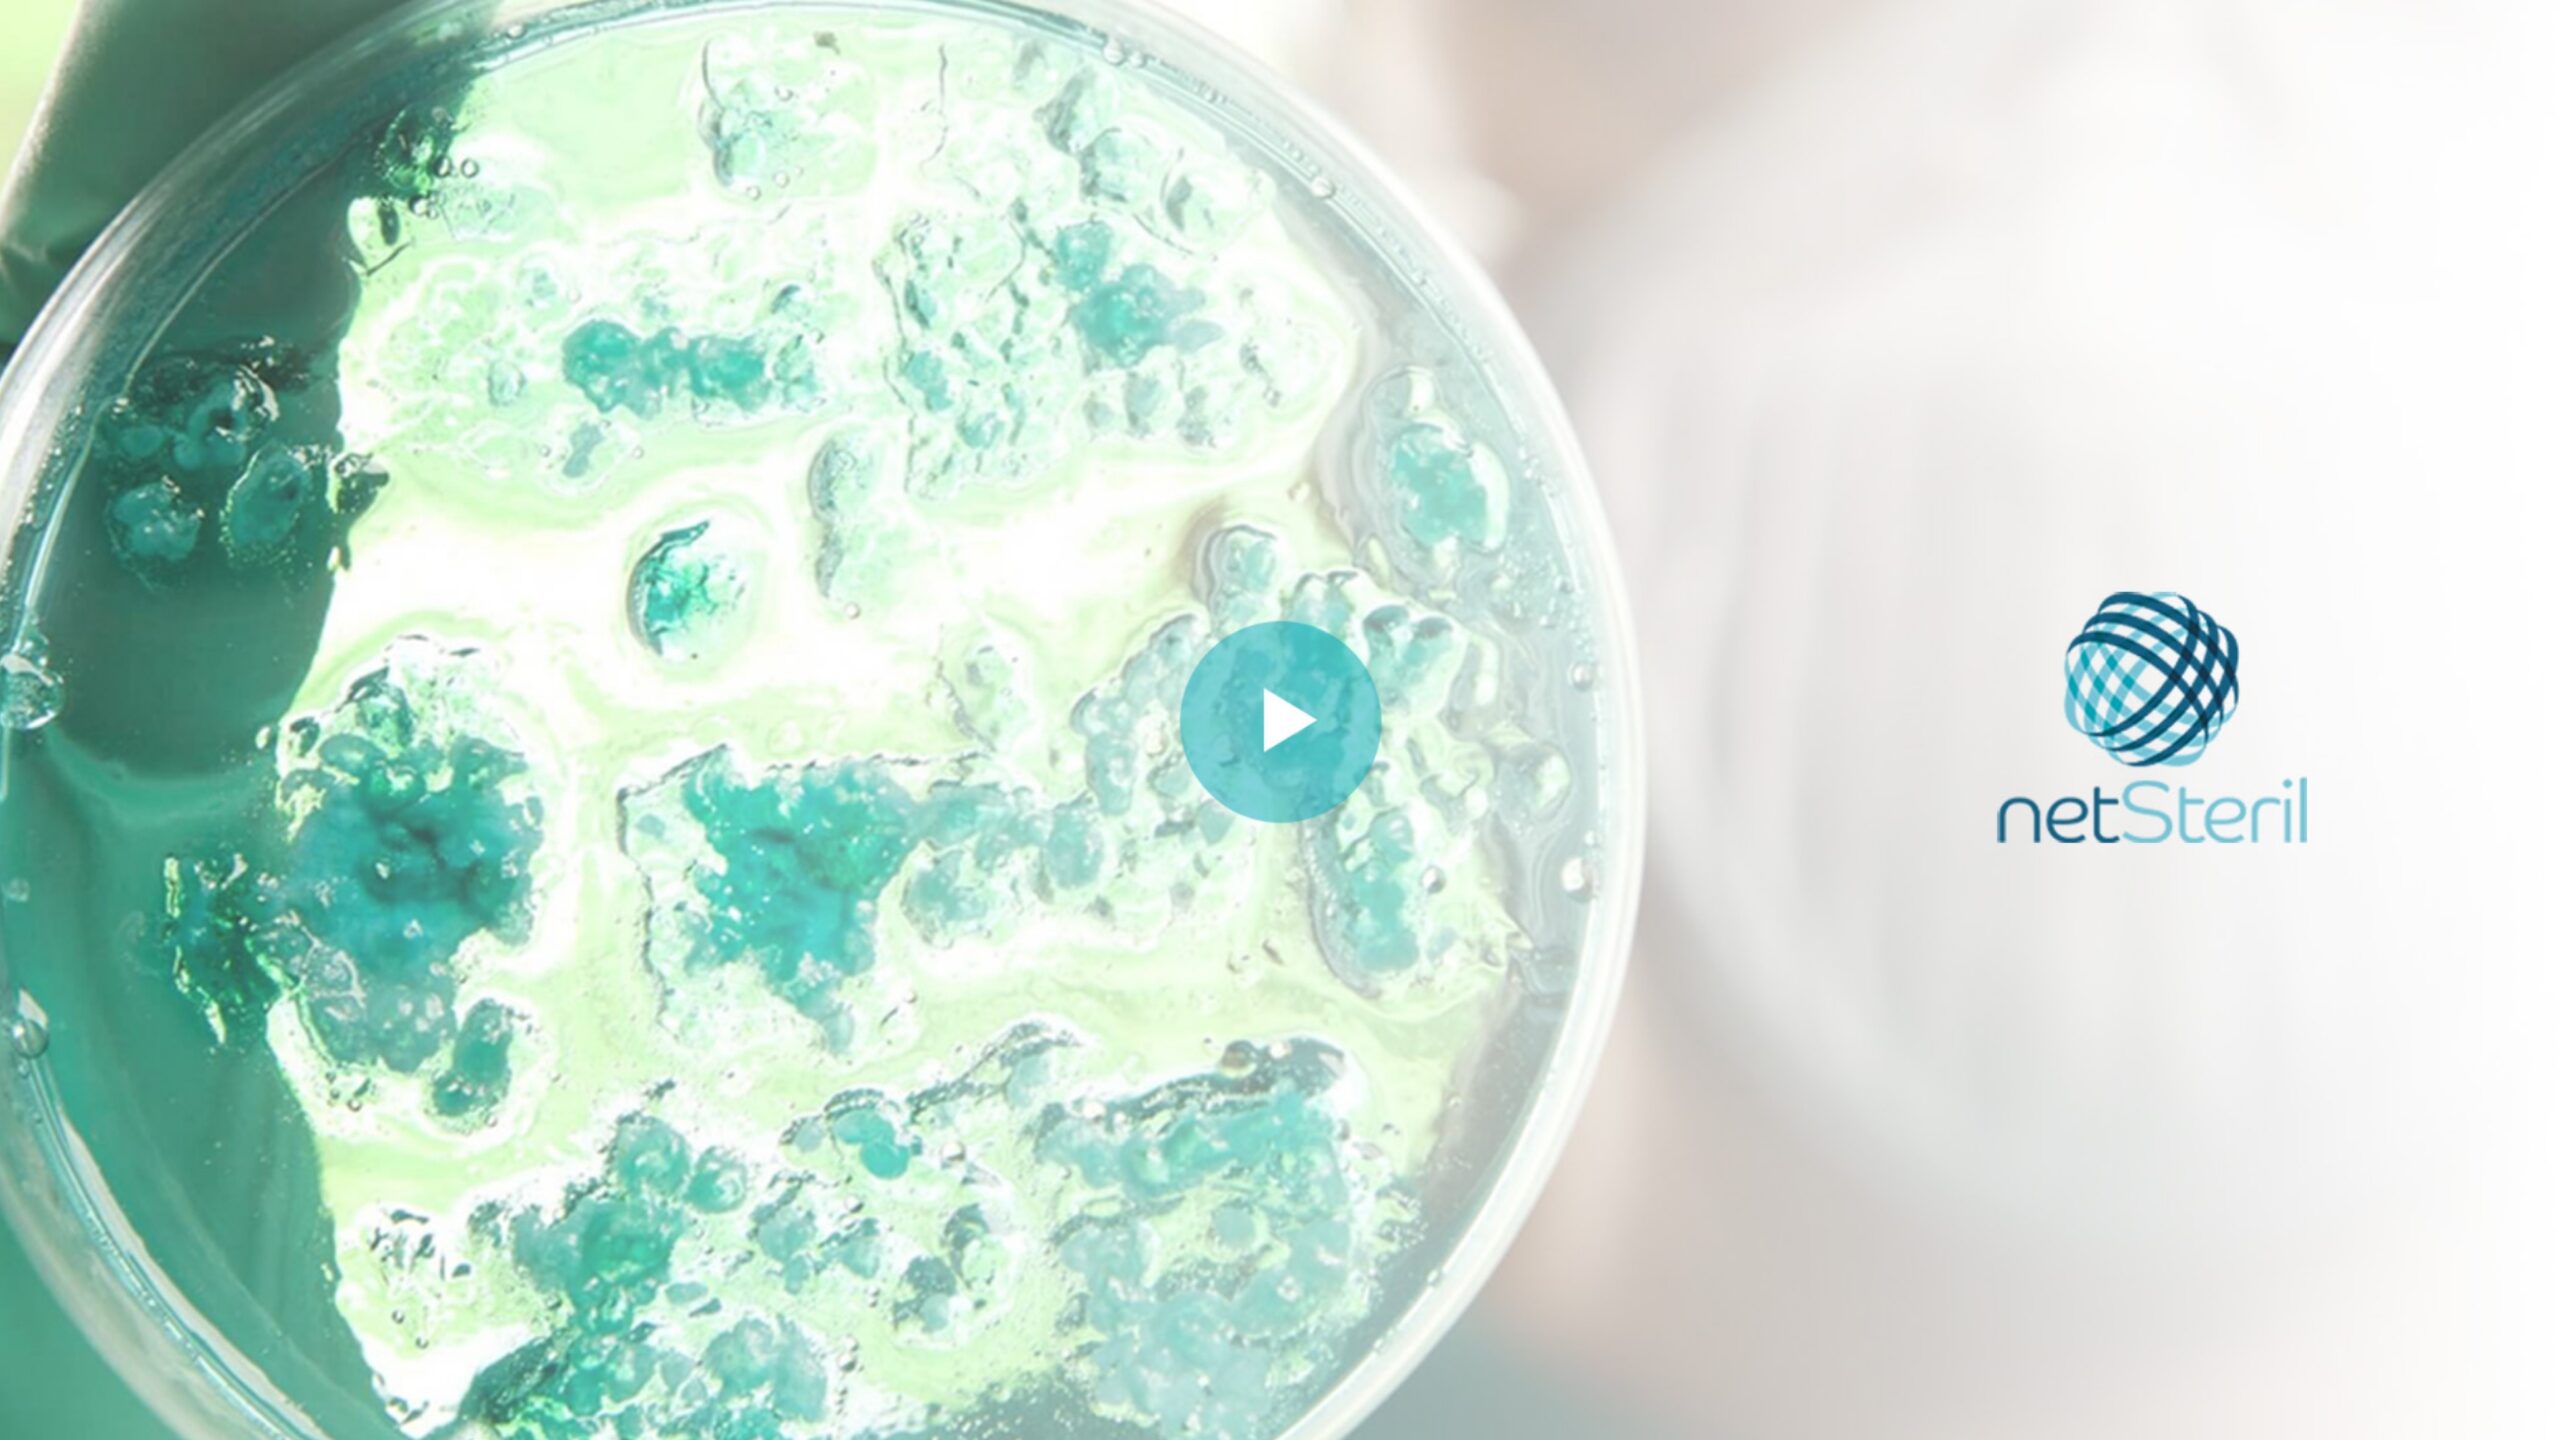
Thumbnail vídeo quienes somos Netsteril

Descubre nuestras soluciones para el control de contaminación

Misión
Añadir el valor de la especialización y de la experiencia en tecnologías de producción GMP Annex 1 para que nuestros clientes obtengan el mayor rendimiento en sus proyectos de inversión en bienes de equipos y consumo de materiales.
Visión
Ser un proveedor referente por su fiabilidad, calidad y servicio en todo lo relacionado con soluciones para el control estratégico de la contaminación y tecnología farmacéutica.
Valores
Creemos en la integridad, la honestidad y la asertividad como principios para establecer relaciones de largo plazo con nuestras empresas colaboradoras y clientes. Nuestro lema; mejor perder una venta que perder un cliente.
Excelencia
Seleccionamos proveedores y marcas representadas que dispongan de un sólido prestigio, referencias contrastadas y que mejor puedan representar nuestros valores.
Algunos de nuestros clientes